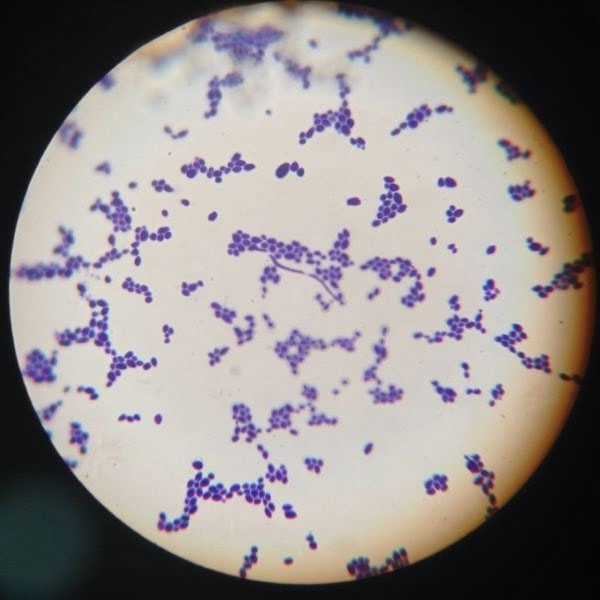
Microscopic view of purple bacteria clusters on a light background, resembling a gram stain, seen through a circular lens.

We have written about ‘leaky gut’ on many occasions in previous blog posts, however up until a few years ago, the exact biochemical processes governing the development of this condition were not really understood. In 2013 however, research published by Alessio Fasano from the University of Maryland School of Medicine1 started to shed some light on the mechanisms behind Leaky Gut syndrome.
Dr Fasano found that a little known molecule called ‘zonulin’ is responsible for opening up the gaps between neighbouring epithelial cells of the gut lining. The purpose of this function is to allow certain nutrients and solutes to get in to and out of the intestine. However, under certain conditions too much zonulin is produced causing the tight junctions between the epithelial cells to open up too much, creating a situation known as 'Leaky Gut'. Overly large gaps between epithelial cells allow bigger food particles such as incompletely digested food proteins to enter the bloodstream, where an immunologic reaction is then initiated against them. Large intra-cellular gaps can also allow leakage of intestinal contents such as bacteria in to the blood stream, creating systemic inflammation and localised damage to the gut epithelia, whilst also over-loading the livers detoxification capabilities.
Within this article:

Wheat and other gluten and gliadin containing grains shown to increase zonulin levels
What triggers the production of excess zonulin?
Based on Dr Fasano’s research, it is now known that the two most powerful triggers for the release of zonulin are the consumption of gliadin and gluten (found in certain grains), and also most forms of dysbiosis, including: SIBO, candida over-growth, fungal over-growth and parasitic infections.
It has long been known that gliadin and gluten trigger auto-immune reactions in people with coeliac disease, however it was only a much more recent, 2006, study2 that clearly showed that gliadin affects zonulin levels even in people without the gene for coeliac disease. The researchers of this study concluded that:
"Based on our results, we conclude that gliadin activates zonulin signalling irrespective of the genetic expression of autoimmunity, leading to increased intestinal permeability to macromolecules."
Excess zonulin linked to auto-immune diseases
Based on available research, an increase in zonulin levels has been linked to a variety of different autoimmune conditions, including: Crohn's disease, Type 1 Diabetes and Inflammatory Bowel Disease. It is my personal view that as research progresses, excessive zonulin levels will be linked to a far wider array of diseases and disorders.
In conclusion to his research Dr Fasano states that:
"Genetic predisposition, mis-communication between innate and adaptive immunity, exposure to environmental triggers, and loss of intestinal barrier function secondary to the activation of the zonulin pathway by food-derived environmental triggers or changes in gut microbiota, all seem to be key ingredients involved in the pathogenesis of inflammation, autoimmunity, and cancer. This new theory implies that once the pathologic process is activated, it is not auto-perpetuating. Rather it can be modulated or even reversed by preventing the continuous interplay between genes and the environment."
I think that this is a very exciting statement, as it potentially gives us a key to unlocking the riddle of autoimmunity. Dr Fasano strongly suggests that if we can prevent the interaction of the gut epithelia with either gliadin or gluten proteins, and also pathogenic microbes such as parasites, fungi, yeasts and pathogenic bacteria then we can prevent the over-production of zonulin, and maintain proper epithelial barrier function.
Based on this, for anyone concerned about excess zonulin levels and leaky gut, diet should be broadly structured around the avoidance of any gluten/gliadin-containing grains and the rebalancing of the intestinal flora. A diet that is low in refined carbohydrates and sugars is advised to prevent the overgrowth of undesirable microbes that all favour sugar as their preferred food source. You can read more about candida and diet here.
In addition, the daily consumption of beneficial ‘live cultures’ either from traditional fermented foods, such as kefir, sauerkraut, kimchi etc, or from the use of a good-quality multi-strain probiotic would be excellent ways to increase the colonies of protective ‘probiotic’ bacteria in the small and large intestines.
Zonulin is a new 'buzz' word in gut health, and with good reason it seems. The more we can get to understand this molecule and its triggers the closer scientists will be to unravelling the mysteries of many auto-immune conditions.